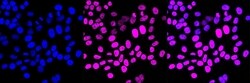
Invitrogen CHD3 Recombinant Rabbit Monoclonal Antibody (23GB1305), Invitrogen

missing translation for 'onlineSavingsMsg'
Learn More
Learn More
Invitrogen™ CHD3 Recombinant Rabbit Monoclonal Antibody (23GB1305), Invitrogen™
Rabbit Recombinant Monoclonal Antibody
Brand: Invitrogen™ MA554097
This item is not returnable.
View return policy
Description
This gene encodes a member of the CHD family of proteins which are characterized by the presence of chromo domains and SNF2-related helicase/ATPase domains. This protein is one of the components of a histone deacetylase complex referred to as the Mi-2/NuRD complex which participates in the remodeling of chromatin by deacetylating histones. Chromatin remodeling is essential for many processes including transcription. Autoantibodies against this protein are found in a subset of patients with dermatomyositis. Three alternatively spliced transcripts encoding different isoforms have been described.
Specifications
| CHD3 | |
| Recombinant Monoclonal | |
| 1.25 mg/mL | |
| PBS with 50% glycerol and 0.02% sodium azide; pH 7.4 | |
| Q12873 | |
| CHD3 | |
| A synthesized peptide derived from human CHD3 (220-300AA). | |
| 20 μL | |
| Primary | |
| Human, Mouse, Rat | |
| Antibody | |
| IgG |
| Flow Cytometry, Western Blot, Immunocytochemistry | |
| 23GB1305 | |
| Unconjugated | |
| CHD3 | |
| 2600010P09Rik; AF020312; ATP-dependent helicase CHD3; CG9594; CG9594-PA; CHD3; CHD-3; Chd3-PA; Chd7; chromodomain helicase DNA binding protein 3; chromodomain-helicase-DNA-binding protein 3; dCHD3; DmCHD3; Dmel\CG9594; Dmel_CG9594; hZFH; MGC40857; Mi 2a; Mi2 ALPHA; Mi-2 alpha; mi-2 autoantigen 240 kDa protein; Mi-2a; Mi2-alpha; Prp7; Prp9 1; Prp9-1; ZFH; Zinc finger helicase; zinc-finger helicase (Snf2-like) | |
| Rabbit | |
| Affinity chromatography | |
| RUO | |
| 1107, 216848, 303241 | |
| -20°C | |
| Liquid |
Product Content Correction
Your input is important to us. Please complete this form to provide feedback related to the content on this product.
Product Title
Spot an opportunity for improvement?Share a Content Correction